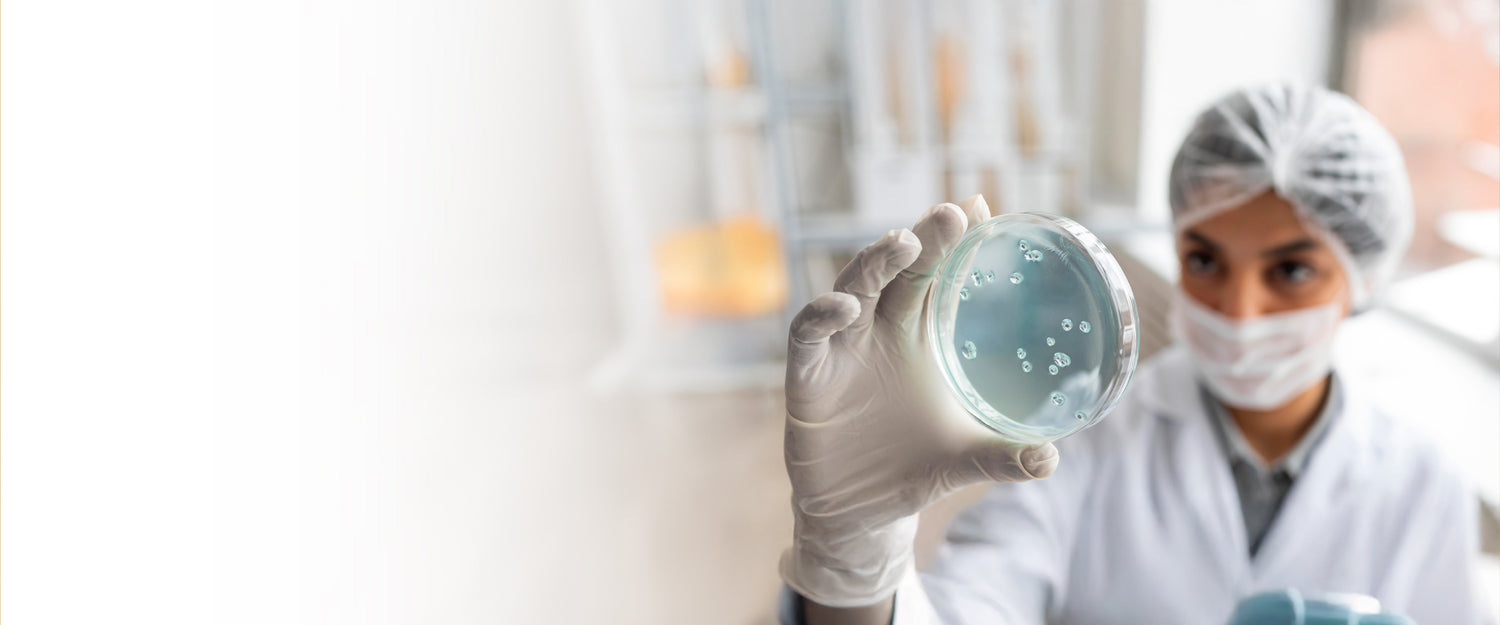
Frequently asked questions on gut microbiome

NIPT (Non Invasive Prenatal Testing)
MapmyBiome: India's Trusted Gut Microbiome Testing Solution
- Regular price
-
Rs. 15,000.00 - Regular price
-
- Sale price
-
Rs. 15,000.00
Couldn't load pickup availability
No coupon is required for the above offers. Offers can be availed directly from payment page.
Non-invasive prenatal screening (NIPS or NIPT), is the first-line screening test globally recommended for detecting common chromosomal abnormalities & microdeletions in fetuses from the cell-free DNA present in the maternal blood sample, passed from the placenta. On average ~10% of the circulating cell-free DNA is found in the maternal blood.2 NIPT is a screening that can be done as early as at 10 weeks of gestation.
[Form-G Mandatory for this test. Form G and Test requisition form by clicking on download sample reports below]
Why NIPT?
NIPT analyzes fetal chromosomal abnormalities using cell-free DNA in the mother's blood, eliminating the need for previously used invasive techniques such as Chorionic Villus sampling or amniocentesis, which carries a high risk of miscarriage. With its non-invasive nature, NIPT provides a solution and reports chromosomal abnormalities with high sensitivity.
It is important to note that NIPT is a screening test and cannot provide a final diagnosis based solely on its results. Nevertheless, NIPT demonstrates great sensitivity in detecting Down syndrome, capturing over 99% of cases3
Conditions screened for
- All autosomal chromosomal abnormalities including trisomies 13, 18, 21
- All sex chromosomal abnormalities
*This test does not reveal the sex of the fetus in accordance with PCPNDT guidelines
Clinical Utility
- NIPT can be performed as early as 10 weeks of gestation, allowing for earlier detection of chromosomal abnormalities compared to traditional screening methods.
- NIPT results can reduce anxiety and uncertainty for expectant parents by providing them with valuable information about their baby's health.
- Reduced invasive tests by 94.8% & decrease in procedure-related miscarriages by 90.8% 4
When is NIPT recommended
- NIPT is generally recommended to all pregnant woman
- If any soft marker tests (double, triple & quadruple marker) suggest for chromosomal abnormalities
- If ultrasound High NT or absent nasal bone suggests for chromosomal abnormalities
- History of a prior pregnancy with a trisomy
MapmyGenome’s Offerings
- Identify risk for all chromosomal abnormalities including trisomy 13, 18, 21 and sex chromosomal aneuploidies.
- Non-invasive, safe and accurate
- High detection rate & Low failure rate
- >99% sensitivity and specificity
Benefits
1. Analyzes fetal chromosomal abnormalities using cell-free DNA in the mother's blood, eliminating the need for invasive techniques which carry a high risk of miscarriage.
2. NIPT chromosomal abnormalities, microdeletions and microduplications with high sensitivity.
3. NIPT can be performed as early as 10 weeks of gestation, allowing for earlier detection of abnormalities compared to traditional screening methods.
4. NIPT results can alleviate anxiety and uncertainty for expectant parents by providing them with valuable information about their baby's health.
Test Specification
| Technique | NGS |
| Variant Types | CNVs |
| TAT | 2 Weeks |
| Sample Requirements | 10 ml maternal blood in streck tube |
As of October, 2020:The American College of Obstetricians and Gynecologists (ACOG) and the Society for Maternal-Fetal Medicine (SMFM) endorse NIPT as having the highest detection rate and lowest false positive rate for the common aneuploidies regardless of maternal age or baseline risk, of all screening options.1
References
-
American College of Obstetricians and Gynecologists’ Committee on Practice Bulletins—Obstetrics; Committee on Genetics; Society for Maternal-Fetal Medicine. Screening for Fetal Chromosomal Abnormalities: ACOG Practice Bulletin, Number 226. Am J Obstet Gynecol. 2020 Oct;136(4):e48-e69.
-
Hou, Y., Yang, J., Qi, Y. et al. Factors affecting cell-free DNA fetal fraction: statistical analysis of 13,661 maternal plasmas for non-invasive prenatal screening. Hum Genomics 13, 62 (2019).
-
Smith, Meagan et al. “A Case of False Negative NIPT for Down Syndrome-Lessons Learned.” Case reports in genetics vol. 2014 (2014): 823504. doi:10.1155/2014/823504
-
Kostenko, Emilia et al. “Clinical and Economic Impact of Adopting Noninvasive Prenatal Testing as a Primary Screening Method for Fetal Aneuploidies in the General Pregnancy Population.” Fetal diagnosis and therapy vol. 45,6 (2019): 413-423. doi:10.1159/000491750
What is the Technique Technique used?
MapMyBiome uses 16S rRNA gene sequencing to analyze bacterial genetic material in the gut.
What can a gut microbiome test reveal?
- The diversity and balance of bacteria in your gut
- Beneficial bacteria levels and potential harmful bacteria overgrowth
- Your gut's ability to produce essential vitamins and nutrients
- Inflammation markers and digestive health indicators
- Metabolic efficiency and weight management factors
- Links to conditions like IBS, bloating, or food sensitivities
- Personalized dietary and probiotic recommendations
What are the core deliverables of the Test?
- Digital reports
- Personalized recommendations for nutrition
- Probiotic suggestions
- Supplement recommendations
- Lifestyle guidance
WHAT ARE THE CORE BENEFITS OF THE TEST?
- Comprehensive gut microbiome analysis
- Identification of potential gut health issues
- Personalized dietary and lifestyle recommendations
How does gut microbiome testing work?
The process involves collecting a small stool sample at home using a provided MyapMyBiome kit, which is then sent to our laboratory. Scientists use next-generation sequencing (NGS) technology to analyze the DNA of microorganisms in your sample. The lab identifies thousands of bacterial species, measures their abundance, and compares your results to healthy reference databases to generate a personalized report with actionable recommendations.
WHAT TYPE OF SAMPLE IS COLLECTED FOR THIS TEST?
Stool sample (non-invasive, at-home collection)
WHO CAN TAKE THIS TEST
- Anyone seeking gut health insights
- People with digestive concerns (bloating, constipation, stomach discomfort)
- Individuals optimizing diet and lifestyle
Those curious about microbiome's influence on health
How do I collect a sample at home?
Sample collection is simple and done at home:
- Receive your sterile collection kit with instructions
- Collect a small stool sample using the provided collection device
- Place the sample in the preservation tube
- Register your kit online with the unique barcode
click here to view the detailed step by step proceducre


NIPT (Non Invasive Prenatal Testing)
- Regular price
-
Rs. 15,000.00 - Regular price
-
- Sale price
-
Rs. 15,000.00
The Advantages of MapmyBiome Test
-
✓ NABL-Accredited Laboratory
Trusted analysis from certified professionals
-
✓ At-Home Convenience
Simple, non-invasive sample collection
-
✓ Comprehensive Report
Detailed digital report on complete gut bacterial analysis
-
✓ Genetic Experts Support
Exclusive guidance from Genetic Counsellor on improving Gut Health

MapMyBiome
India's only NABL/CAP accredited gut microbiome testing with a decade of genomics expertise, gives you comprehensive Gut Bacteria Report with free genetic counseling, and personalized recommendations to improve your Gut health

What is Gut Microbiome Testing
Gut microbiome testing represents a revolutionary approach to understanding and optimizing your health from the inside out. By revealing the hidden world of microorganisms that profoundly influence your wellbeing, this innovative testing empowers you to make evidence-based decisions about your diet, lifestyle, and healthcare. Whether you're addressing specific health concerns or proactively optimizing your wellness, gut microbiome testing provides the personalized insights you need to take control of your health journey.
Everything You Need to Know About Gut Microbiome Testing
Your complete guide to understanding, testing, and improving your gut health.

